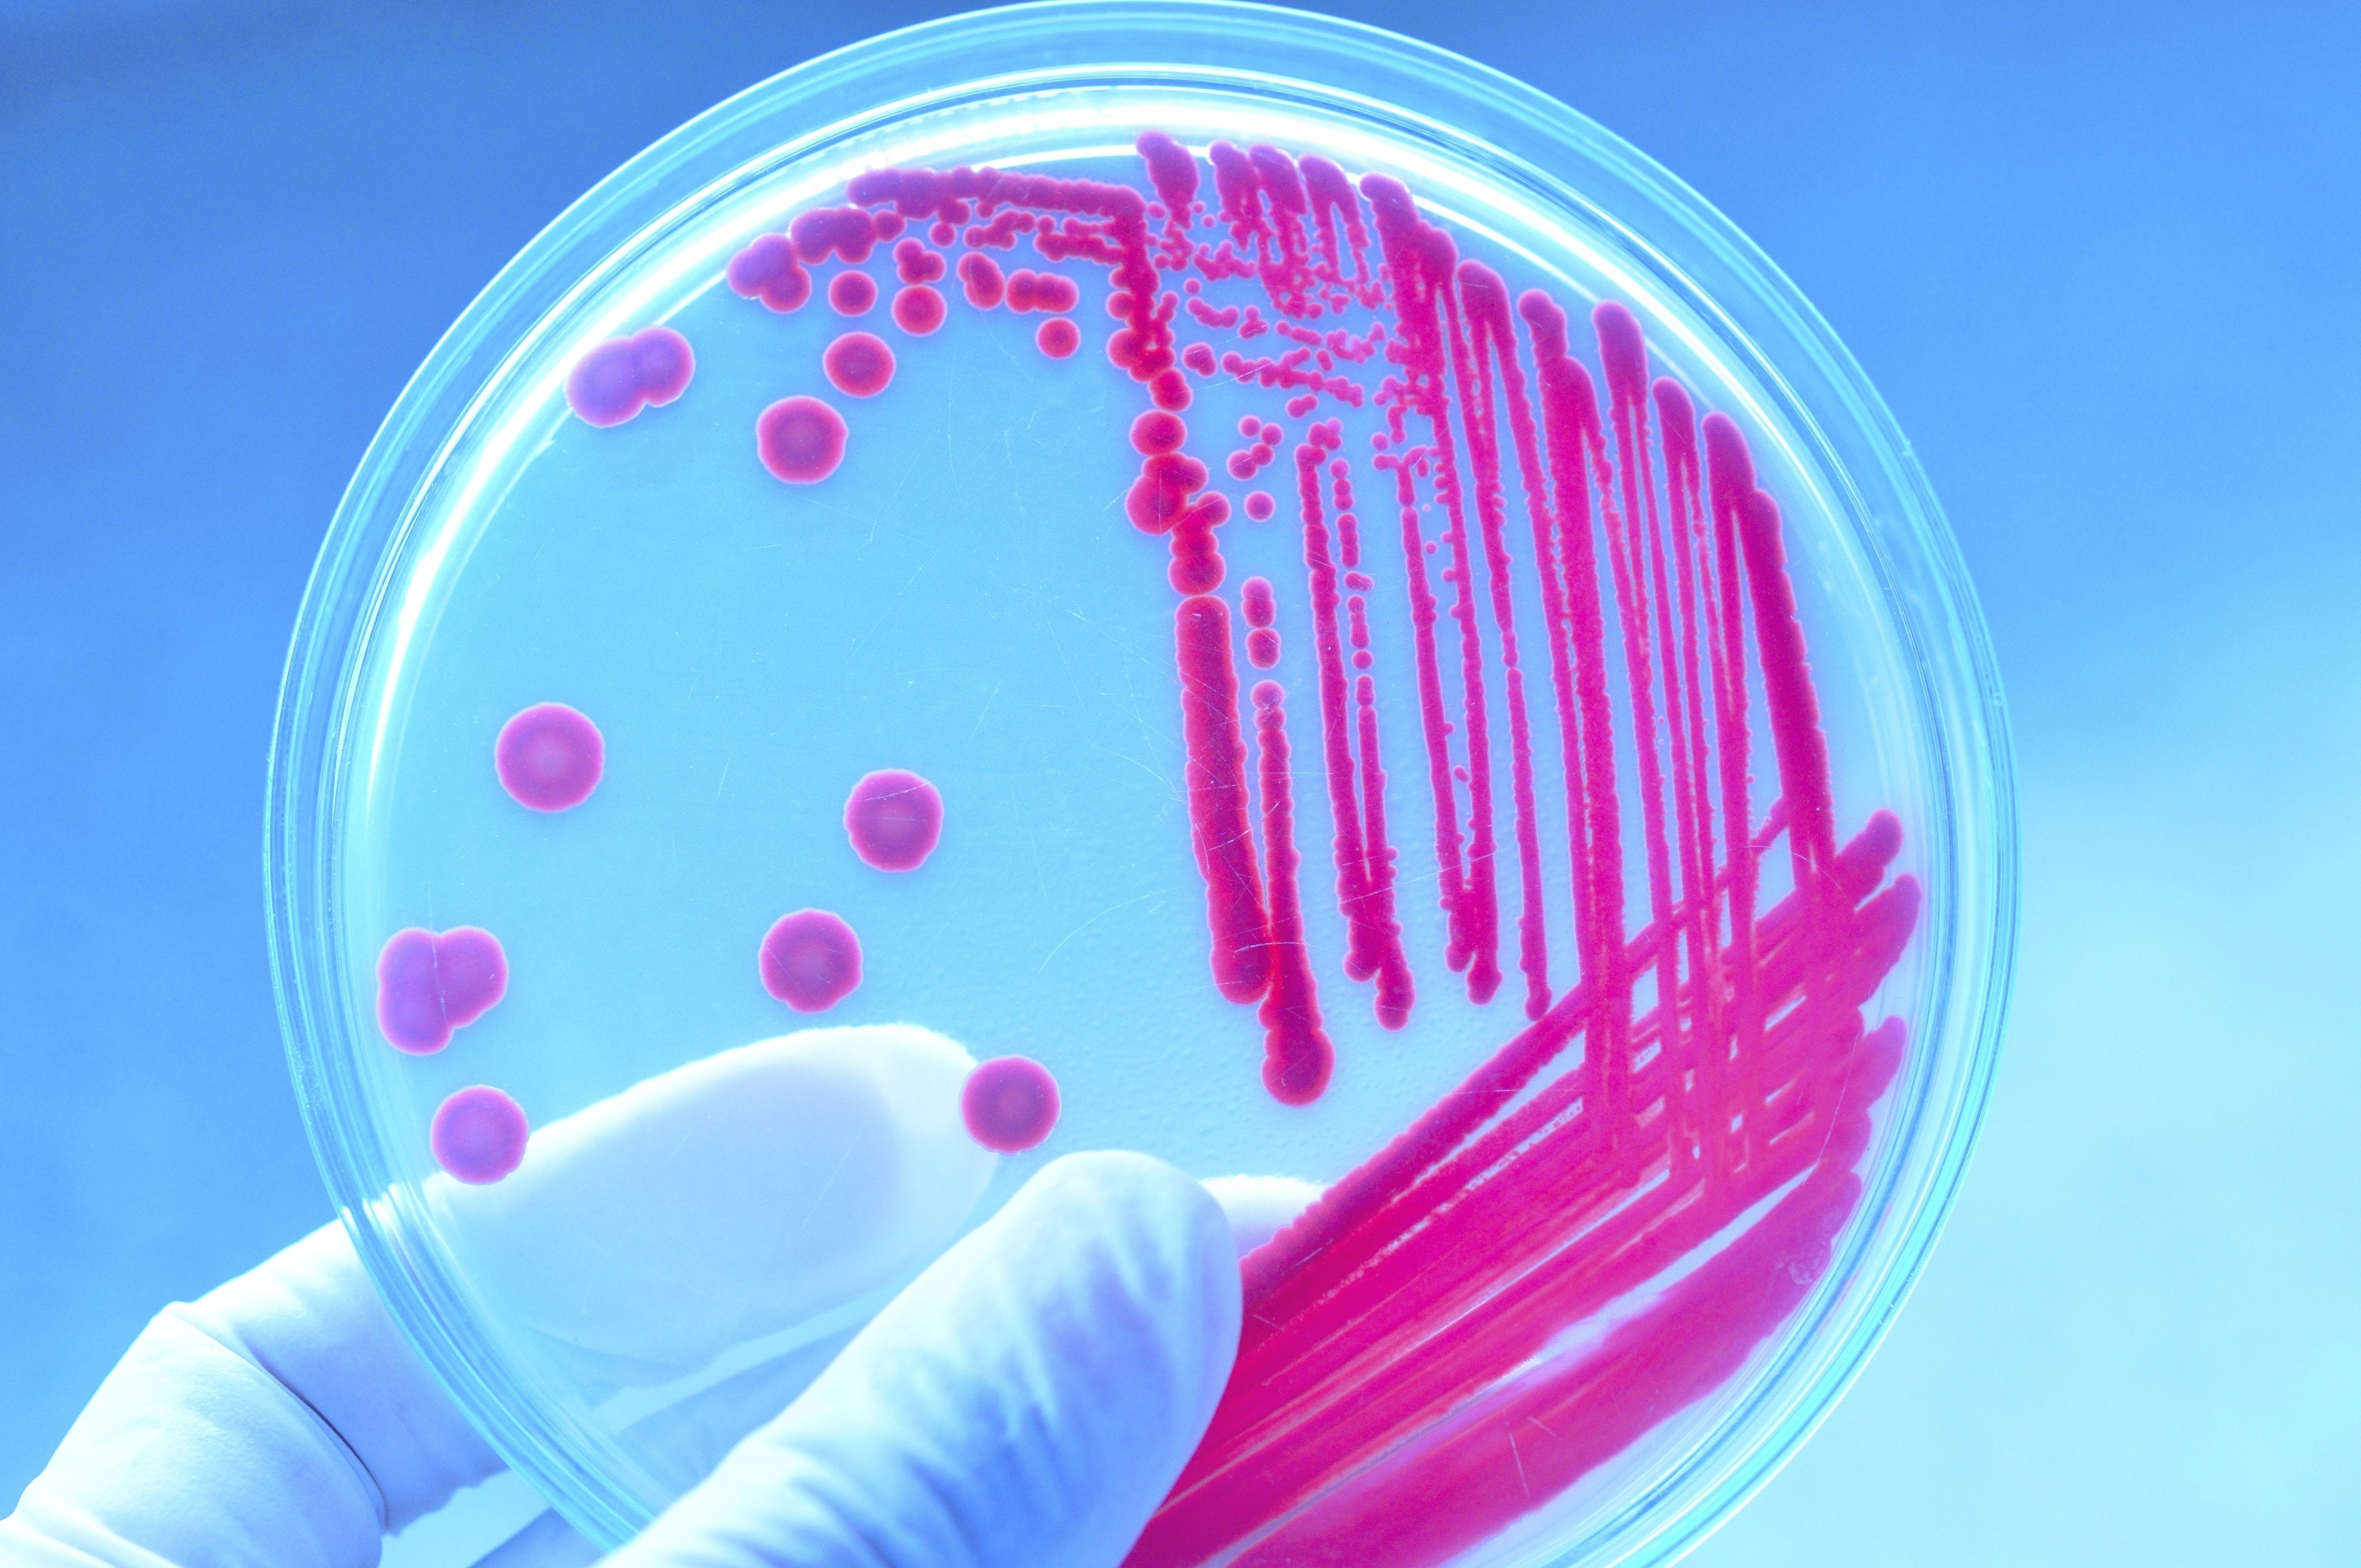

Тец микробиология
Шейдеры на фордж 1.21
Восстановить хром своими руками
Перчатки чистюля
B222100000494
Бассейн казьминка
Дас бир
Как обустроить дом начальный в адопт ми
Вопросы по теме нервная система 9 класс
Раскинуть умом
На каких свойствах веществ основано применение алюминия
Слеза бога что это
На что ловить судака реальной рыбалке
Решение 193
Тец микробиология 112 фотографий